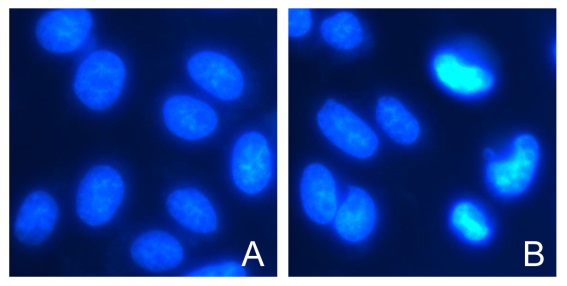
活细胞染色液(Hoechst 33342)(100×)现货供

相关产品推荐更多 >
万千商家帮你免费找货
0 人在求购买到急需产品
- 详细信息
- 技术资料
- 库存:
466
- 英文名:
Hoechst 33342 Living Cell Staining Solution
- 保质期:
一年
- 供应商:
北京百奥莱博科技有限公司
- 保存条件:
-20℃
特别声明:本产品及我公司所售其他产品均为科研类试剂产品,严禁用于药物、医疗及其他非科研用途。
北京百奥莱博专业生产供应活细胞染色液(Hoechst 33342)(100×)现货供应,我公司销*(代"售")全品类的细胞生物学试剂,价格优惠,欢迎广大科研工作者垂询订购。
名称:活细胞染色液(Hoechst 33342)(100×)现货供应
规格:0.1ml|0.5ml|3ml
品牌:百奥莱博
编号:YT896
英文名:Hoechst 33342 Living Cell Staining Solution
产地:国产|进口
本品是一种适用于活细胞细胞核染色的溶液。仅需染色10分钟就能用荧光显微镜观察到非常明亮的细胞核蓝色荧光染色。 本产品也适用于固定后的细胞或组织的细胞核染色。
CAS:23491-52-3
分子式:C27H28N6O·3HCl·3H2O
分子量:615.99
激发和发射波长:346nm,460nm
激发和发射波长(和双链DNA结合后):350nm,461nm
Hoechst 33342是一种可以穿透细胞膜的蓝色荧光染料,对细胞的毒性较低。Hoechst 33342染色常用于细胞凋亡检测,染色后用荧光显微镜观察或流式细胞仪检测。Hoechst 33342也常用于普通的细胞核染色,或常规的DNA染色。本产品用于活细胞染色的效果图参考下图。
正常培养的HeLa细胞用本产品染色后的实拍效果图。图A为正常细胞Hoehst 33342的染色效果图。图B中除了正常细胞外,还清晰可见呈现致密浓染的凋亡细胞。
注意事项:
1. 本产品浓度经过百奥莱博的优化,确保可以满足活细胞染色及各种常规染色的需要。如需使用特定浓度的Hoechst 33342,请选购百奥莱博的粉末装Hoechst 33342 (YT894)。
2. 荧光染料都存在淬灭的问题,建议染色后尽量当天完成检测。活细胞或组织染色后宜立即观察。
3. 为减缓荧光淬灭可以使用抗荧光淬灭封片液。抗荧光淬灭封片液(YT097)可以向百奥莱博订购。
储存条件:-20℃避光,有效期一年。
欲咨询购买活细胞染色液(Hoechst 33342)(100×)现货供应,请致电北京百奥莱博科技有限公司,为您提供最全面周到的产品服务,除此之外,我公司正在促销以下产品:
ARB10584 人延伸蛋白A(EloA)含量测试 Human elongin a,eloa ELISA KIT
ARB10881 人抗脊髓灰质炎病毒(PV-Ab)检测服务 Human anti-poliomyelitis virus antibody ELISA KIT
ARB13158 小鼠结合珠蛋白/触珠蛋白(Hpt/HP)ELISA代测服务 Mouse haptoglobin,hpt/hp ELISA KIT
ARB14082 犬核因子Kb(NFKb)Elisa定量检测
β-葡聚糖酶 Span 40 9025-70-1
甲基-β-D-葡糖苷 Octadecylamine 709-50-2
抗体储存液 100ml
ARB10971 人免疫球蛋白G Fc段受体Ⅱ(FcγRⅡ/CD32)Elisa定量检测 Human receptor Ⅱ for the fc region of immunoglobulin g,fcγrⅡ ELISA KIT
BTN120930 分子杂交炉 Hybridization Oven
蔗糖酶 Sepharose CL-6B 9001-57-4
ARB14088 牛结核病抗体免费代测
ARB13650 兔子碱性成纤维细胞生长因子(bFGF)检测服务 Rabbit basic fibroblast growth factor,bfgf ELISA KIT
ARB10636 人血管内皮生长因子165(VEGF165)Elisa方法检测 Human vascular endothelial growth factor165,vegf165 ELISA KIT
BL1065 MH(A)培养基
ARB13385 牛棘球蚴(echInococcIosIs)代做ELISA实验
ARB13524 兔6酮前列腺素F1A(6-keto-PGF1A)ELISA检测服务 Rabbit 6-keto-prostaglandin f1a,6-k-pgf1a ELISA KIT
N-癸酰基-N-甲基葡糖胺 Pyridine hydrochloride 85261-20-7
活细胞染色液(Hoechst 33342)(100×)现货供应关键词:Hoechst 33342 Living Cell Staining Solution,活细胞染色液(Hoechst 33342)(100×),23491-52-3
Ehrlich试剂 100ml|500ml
14306-25-3 植酸*
ARB13190 小鼠胰岛素原(PI)elisa检测 Mouse proinsulin,pi ELISA KIT
ARB11155 人周期素依赖性激酶1(CDK-1)Elisa方法检测 Human cyclin-dependent kinase 1,cdk-1 ELISA KIT
BL1257 250bp DNA Ladder
HC0117 透析袋MD27 ( 截留量500)
C:I(24:1) 100ml
BFD005 猪伪狂犬病毒抗体检测试剂盒
ARB12448 大鼠*结合蛋白(CR)酶免分析 Rat calretinin,cr ELISA KIT
葡萄糖氧化酶 Sephadex G-50 9001-37-0
PY02-012 乳糖培养基 250克
利福平溶液(50mg/ml) Rifampicin 50mg/ml 10ml
BL0872 羊抗猪IgG免疫血清
间甲*甲*(代"酸") Trifluorothymidine 99-04-7
Hanks平衡盐粉剂(含酚红) 1×HBSS 1L|10×1L
N-乙酰-L-异亮*酸 DL-5-HTP 3077-46-1
柠檬酸铋 Potassium sulfate 813-93-4
BL1335 通用引物 ITS4
活细胞染色液(Hoechst 33342)(100×)现货供应关键词:Hoechst 33342 Living Cell Staining Solution,活细胞染色液(Hoechst 33342)(100×),23491-52-3
·兔抗MMP2抗体
编号:YT742
英文名称:MMP2 Rabbit Polyclonal Antibody
规格:50μl
本品为来源于兔的抗MMP2的多克隆抗体。
宿主:兔
克隆性:多克隆抗体
用途:WB,FC, IHC,ICC, IF
交叉反应性:人,小鼠,大鼠
分子量:74KDa
推荐稀释比例:WB(1:1000),IF(1:200),IHC(1:200),ICC(1:200),FC(1:100)
| About this Antibody | |
| Name | MMP2 Rabbit Polyclonal Antibody |
| Category | Polyclonal antibody(pAb); Primary antibody |
| Isotype | IgG |
| Purification | Peptide affinity purified |
| About the Immunogen | |
| Immunogen | This antibody is produced by immunizing rabbits with a synthetic peptide (KLH-coupled) corresponding to MMP2. |
| Gene ID | 4313 |
| SwissProt | P08253 |
| Synonyms | CLG4; MONA; CLG4A; TBE-1; MMP-II |
| Category | Adhesion/ECM |
| Background | Proteins of the matrix metalloproteinase (MMP) family are involved in the breakdown of extracellular matrix in normal physiological processes, such as embryonic development, reproduction, and tissue remodeling, as well as in disease processes, such as arthritis and metastasis. Most MMP"s are secreted as inactive proproteins which are activated when cleaved by extracellular proteinases. Activation of MMP-2 requires proteolytic processing. A complex of membrane type 1 MMP (MT1-MMP/MMP14) and tissue inhibitor of metalloproteinase 2 recruits pro-MMP 2 from the extracellular milieu to the cell surface. Activation then requires an active molecule of MT1-MMP and auto catalytic cleavage. Clustering of integrin chains promotes activation of MMP-2. Mutations in the MMP2 gene are associated with Torg-Winchester syndrome, multicentric osteolysis, arthritis syndrome, and possibly keloids. |
注意事项:
1. 如果本抗体用于Western blot (WB)、免疫荧光(IF)、免疫细胞化学(ICC)等实验,请注意回收使用过的稀释抗体。回收的抗体通常至少可以重复使用5-10次。稀释后的抗体,包括已经使用过的稀释抗体,请4℃保存。
2. 回收后重复使用的抗体,使用方法同新鲜稀释的抗体。如果在重复使用过程中发现抗体出现轻微混浊现象,可以10,000g离心1-3分钟,取上清用于后续检测。如果回收的抗体出现明显的絮状物或长霉长菌等情况,则可以考虑废弃该抗体。
3. 提供的Western一抗稀释液也可以用于免疫荧光(IF)、免疫组化(IHC)、免疫细胞化学(ICC)等适当用途。如果希望获得最佳的检测效果,请考虑使用上述检测专用的一抗稀释液。
储存条件:-20℃,有效期一年。
我公司强烈推荐细胞凋亡与增殖系列产品,热情期待您的咨询选购活细胞染色液(Hoechst 33342)(100×)现货供应。
风险提示:丁香通仅作为第三方平台,为商家信息发布提供平台空间。用户咨询产品时请注意保护个人信息及财产安全,合理判断,谨慎选购商品,商家和用户对交易行为负责。对于医疗器械类产品,请先查证核实企业经营资质和医疗器械产品注册证情况。
 技术资料
技术资料暂无技术资料 索取技术资料









